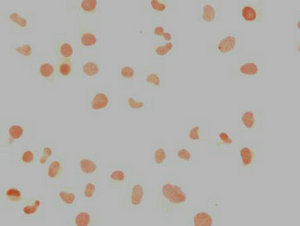

NANOG Monoclonal Antibody
-
中文名稱:NANOG鼠單克隆抗體
-
貨號:CSB-MA888008A0m
-
規格:¥1320
-
圖片:
-
Western Blot
Positive WB detected in: Rat brain tissue, Mouse brain tissue
All lanes: NANOG antibody at 1:500
Secondary
Goat polyclonal to Mouse IgG at 1/10000 dilution
Predicted band size: 35, 33 kDa
Observed band size: 46, 42 kDa -
Western Blot
Positive WB detected in: MCF-7 whole cell lysate, Ntera-2 whole cell lysate, A549 whole cell lysate
All lanes: NANOG antibody at 1:500
Secondary
Goat polyclonal to Mouse IgG at 1/10000 dilution
Predicted band size: 35, 33 kDa
Observed band size: 46, 40 kDa -
Immunocytochemistry analysis of CSB-MA888008A0m diluted at 1:100 and staining in Hela cells performed on a Leica BondTM system. The cells were fixed in 4% formaldehyde, permeabilized using 0.2% Triton X-100 and blocked with 10% normal goat serum 30min at RT. Then primary antibody (1% BSA) was incubated at 4°C overnight. The primary is detected by a biotinylated secondary antibody and visualized using an HRP conjugated SP system.
-
Immunocytochemistry analysis of CSB-MA888008A0m diluted at 1:100 and staining in Ntera-2 cells performed on a Leica BondTM system. The cells were fixed in 4% formaldehyde, permeabilized using 0.2% Triton X-100 and blocked with 10% normal goat serum 30min at RT. Then primary antibody (1% BSA) was incubated at 4°C overnight. The primary is detected by a biotinylated secondary antibody and visualized using an HRP conjugated SP system.
-
Immunofluorescence staining of Hela cells with CSB-MA888008A0m at 1:100, counter-stained with DAPI. The cells were blocked in 10% normal Goat Serum and then incubated with the primary antibody overnight at 4°C. The secondary antibody was Alexa Fluor 488-congugated AffiniPure Goat Anti-Mouse IgG(H+L).
-
Immunofluorescence staining of Ntera-2 cells with CSB-MA888008A0m at 1:100, counter-stained with DAPI. The cells were blocked in 10% normal Goat Serum and then incubated with the primary antibody overnight at 4°C. The secondary antibody was Alexa Fluor 488-congugated AffiniPure Goat Anti-Mouse IgG(H+L).
-
Overlay histogram showing Hela cells stained with CSB-MA888008A0m (red line) at 1:250. The cells were incubated in 1x PBS /10% normal goat serum to block non-specific protein-protein interactions followed by primary antibody for 1 h at 4°C. The secondary antibody used was FITC goat anti-mouse IgG(H+L) at 1/200 dilution for 1 h at 4°C. Isotype control antibody (green line) was used under the same conditions. Acquisition of >10,000 events was performed.
-
Overlay histogram showing MCF-7 cells stained with CSB-MA888008A0m (red line) at 1:250. The cells were incubated in 1x PBS /10% normal goat serum to block non-specific protein-protein interactions followed by primary antibody for 1 h at 4°C. The secondary antibody used was FITC goat anti-mouse IgG(H+L) at 1/200 dilution for 1 h at 4°C. Isotype control antibody (green line) was used under the same conditions. Acquisition of >10,000 events was performed.
-
Overlay histogram showing Ntera-2 cells stained with CSB-MA888008A0m (red line) at 1:250. The cells were incubated in 1x PBS /10% normal goat serum to block non-specific protein-protein interactions followed by primary antibody for 1 h at 4°C. The secondary antibody used was FITC goat anti-mouse IgG(H+L) at 1/200 dilution for 1 h at 4°C. Isotype control antibody (green line) was used under the same conditions. Acquisition of >10,000 events was performed.
-
-
其他:
產品詳情
-
產品描述:CUSABIO貨號:CSB-MA888008A0m NANOG單克隆抗體是針對多能性調控核心因子NANOG研發的高特異性科研試劑,可識別人、小鼠、大鼠種屬的NANOG蛋白。該抗體經嚴格驗證適用于ELISA、Western Blot、免疫細胞化學(ICC)、免疫熒光(IF)及流式細胞術(FC)等多種實驗平臺。NANOG作為維持胚胎干細胞自我更新和多能性的關鍵轉錄因子,在腫瘤干細胞特性維持及癌癥轉移機制研究中具有重要價值。本產品采用雜交瘤技術制備,具有高親和力與低交叉反應性特點,適用于干細胞重編程研究、腫瘤異質性分析以及發育生物學領域的蛋白表達檢測。在實驗設計中可配合多種裂解液體系使用,支持細胞裂解液、組織樣本等多種來源的蛋白檢測需求,為探索NANOG在細胞命運決定、癌癥發生發展中的作用提供可靠工具。該抗體特別適用于多能性標志物共定位分析、腫瘤干細胞分選及體外分化研究,滿足再生醫學、腫瘤微環境等前沿領域的科研需求。
-
產品名稱:Mouse anti-Homo sapiens (Human) NANOG Monoclonal antibody
-
Uniprot No.:
-
基因名:
-
別名:Embryonic stem cell specific homeobox protein (Nanog) antibody; ENK antibody; FLJ12581 antibody; hNanog antibody; Homeobox protein NANOG antibody; Homeobox transcription factor Nanog antibody; homeobox transcription factor Nanog-delta 48 antibody; NANOG antibody; Nanog homeobox antibody; NANOG_HUMAN antibody
-
宿主:Mouse
-
反應種屬:Human, Mouse, Rat
-
免疫原:Recombinant Human Homeobox protein NANOG protein (1-305AA)
-
免疫原種屬:Homo sapiens (Human)
-
標記方式:Non-conjugated
-
克隆類型:Monoclonal
-
抗體亞型:IgG1
-
純化方式:>95%, Protein G purified
-
克隆號:8A1D11
-
濃度:It differs from different batches. Please contact us to confirm it.
-
保存緩沖液:Preservative: 0.03% Proclin 300
Constituents: 50% Glycerol, 0.01M PBS, PH 7.4 -
產品提供形式:Liquid
-
應用范圍:ELISA, WB, ICC, IF, FC
-
推薦稀釋比:
Application Recommended Dilution WB 1:500-1:2000 ICC 1:50-1:500 IF 1:50-1:200 -
Protocols:
-
儲存條件:Upon receipt, store at -20°C or -80°C. Avoid repeated freeze.
-
貨期:Basically, we can dispatch the products out in 1-3 working days after receiving your orders. Delivery time maybe differs from different purchasing way or location, please kindly consult your local distributors for specific delivery time.
-
用途:For Research Use Only. Not for use in diagnostic or therapeutic procedures.
相關產品
靶點詳情
-
功能:Transcription regulator involved in inner cell mass and embryonic stem (ES) cells proliferation and self-renewal. Imposes pluripotency on ES cells and prevents their differentiation towards extraembryonic endoderm and trophectoderm lineages. Blocks bone morphogenetic protein-induced mesoderm differentiation of ES cells by physically interacting with SMAD1 and interfering with the recruitment of coactivators to the active SMAD transcriptional complexes. Acts as a transcriptional activator or repressor. Binds optimally to the DNA consensus sequence 5'-TAAT[GT][GT]-3' or 5'-[CG][GA][CG]C[GC]ATTAN[GC]-3'. Binds to the POU5F1/OCT4 promoter. Able to autorepress its expression in differentiating (ES) cells: binds to its own promoter following interaction with ZNF281/ZFP281, leading to recruitment of the NuRD complex and subsequent repression of expression. When overexpressed, promotes cells to enter into S phase and proliferation.
-
基因功能參考文獻:
- The critical roles of NANOG and its pseudogene NANOGP8 in cancer progression leads the association of these genes with exosomes to be significant, and may allow for exosomal NANOG to function as a powerful diagnostic biomarker. Variations in NANOG/NANOGP8 gene sequences in exosomal DNA includes an insertion into the 3' UTR. PMID: 29787607
- A higher expression of the pluripotency factor NANOG. PMID: 29845283
- The interaction of Nanog with the AR signaling axis might induce or contribute to Ovarian cancer stem cells regulation. In addition, androgen might promote stemness characteristics in ovarian cancer cells by activating the Nanog promoter PMID: 29716628
- The results show that Nanog expression was related to HBsAg, differentiation, and TNM stage in hepatocellular carcinoma (HCC). Nanog may be an unfavorable prognostic biomarker for HCC. PMID: 29198990
- NANOG might be a potential biomarker for early diagnosis of urothelial carcinoma of the bladder. PMID: 29279584
- These results demonstrate that analysis of IHC expression patterns of MK and NANOG in pretreatment biopsy specimens during the work-up period can provide a more definitive prognosis prediction for each oral squamous cell carcinoma (OSCC) patient that can help clinicians to develop a more precise individual treatment modality. PMID: 29113102
- Chicken egg-white extracts promote OCT4 and NANOG expression and telomeres growth in 293T cells. PMID: 28838341
- Rectal tumor tissue OCT4 (p<0.001), SOX2 (p=0.003), and NANOG (p<0.001) expressions were higher than those in adjacent tissue. PMID: 29214774
- Data show that lung adenocarcinoma SPC-A1 cell differentiated by a two-stage induction (TSI) method lost stem cell characteristics, including absent expression of OCT4 and Nanog. PMID: 27588392
- our data suggest that 3D culture increases the expression of Nanog through the relaxation of actin cytoskeleton, which mediates reduced Suv39h1 and H3K9me3 levels. PMID: 28276635
- results show that NANOG could reverse the effects of stem cell senescence and restore the myogenic differentiation potential of senescent MSCs. PMID: 28125933
- MACC1-induced tumor progression in colorectal cancer acts, at least in part, via the newly discovered MACC1/Nanog/Oct4 axis. PMID: 26758557
- RNAi-mediated silencing of NANOG in SKOV-3 reversed the expression of mesenchymal cell markers and restored expression of E-cadherin. Susceptibility to cisplatin increased in SKOV-3 cells on down-regulating NANOG and reversible results were obtained in Moody cells post-overexpression of NANOG. PMID: 27884977
- NANOG enabled reactivation of the ROCK and Transforming Growth Factor (TGF)-beta pathways-both of which were impaired in senescent cells-leading to ACTIN polymerization, MRTF-A translocation into the nucleus and serum response factor (SRF)-dependent myogenic gene expression. PMID: 27350449
- High NANOG expression is associated with brain neoplasms. PMID: 28933914
- Super-enhancers at the Nanog locus differentially regulate neighboring pluripotency-associated genes, in particular, DPPA3. PMID: 27681417
- our data reveal that SATB2 in alveolar bone mesenchymal stem cells (AB-BMSCs) associates with their age-related properties, and prevents AB-BMSCs senescence via maintaining Nanog expression. PMID: 27632702
- High NANOG expression is associated with Multidrug Resistance in breast and cervical cancer. PMID: 28716899
- miR-612 has a suppressive role on hepatocellular carcinoma cell stemness via Sp1/Nanog signaling pathway. PMID: 27685621
- These data reveal an overexpression of NANOG and other markers of pluripotency and stemness in meningiomas. PMID: 28345785
- The NANOG deficiency affected multiple genes, particularly, supressed drug-resistance via down-regulated ABCG2 in Eca109 cells, and caused G1 arrest by down-regulated cyclin D1 (CCND1) expression. PMID: 28601640
- Endogenous Plastic Somatic (ePS) cells in a latent state, i.e. lacking SOX2, OCT3/4 and NANOG (SON) expression, in non-diseased breast specimens through immunohistochemical analysis of previously identified ePS-specific biomarkers (CD73(+), EpCAM(+) and CD90(-)). PMID: 27705752
- Data suggest that C-terminal truncated hepatitis B virus X protein (HBx-DeltaC1) enhances liver cancer stem cell (CSC) properties through Stat3/Nanog cascade, and insight for the therapeutic intervention for hepatitis B virus (HBV)-related hepatocellular carcinoma (HCC). PMID: 28186991
- Nanog directly repressed transcription of the miR-200c and miR-200b genes in colon cancer cells, inducing epithelial-mesenchymal transformation. PMID: 28163188
- LGR5-expressing fraction of CD54+ cells represents gastric cancer CSCs, in which LGR5 is closely associated with stemness and EMT core genes PMID: 28033430
- Data show that Nanog homebox (NANOG) but not sex-determining region Y-box2 (SOX2) and octamer-binding protein 4 (OCT4) expression was overexpressed in the endometrium of women with intrauterine adhesion (IUA). PMID: 28253866
- The NANOG transcription was significantly upregulated by ETV4 overexpression. PMID: 28412366
- Collectively, these findings demonstrate a novel role of YBX1 in maintaining the stemness of CSCs and metastasis, unveiling YBX1 as promising therapeutic target for NSCLC treatments. PMID: 28400280
- the early response of pluripotency genes OCT4 and NANOG to the differentiation-inducing stimuli is mediated by dynamic changes in chromatin marks, while DNA methylation is acquired in the later stages of neurogenesis. PMID: 28601081
- USP21 specifically regulates the Lys48-linked polyubiquitination and stability of NANOG PMID: 27956178
- To our knowledge, this is the first report on lineage reprogramming of TILs using protein stem cell transcription factors delivered directly to the nucleus. PMID: 27084449
- Nanog expression is a prognostic biomarkers for triple-negative breast cancer PMID: 27300169
- Stat3 was correlated with NANOG-mediated EMT. PMID: 26801672
- miR-760 was proved to be functional associated with NANOG via regulating its expression. PMID: 27133070
- SIRT-1 and NANOG are high correlated biological markers for diagnosis and prognosis follow up in patients with adenocarcinoma. PMID: 27540973
- renal cell carcinoma patients with low Nanog and Oct4 expressions in tumor tissues had significantly higher survival rates (p < 0.05). High Nanog and Oct4 expressions may be potential therapeutic targets. PMID: 26631537
- ANOG was regulated by extracellular IGF signaling pathway via STAT3 phosphorylation in colorectal cancer (CRC). This coincides with that IGF receptor IGF-1R is often increasing expressed in malignant metastasis colon cancer. Taken together, our data define the crucial functions of IGF/STAT3/NANOG/Slug signaling axis in the progression of CRC PMID: 26840943
- Nanog is a positive regulator of cervical cancer dedifferentiation. PMID: 26936116
- Data show that long intergenic non-protein coding RNA ROR may act as a competitive endogenous RNAs (ceRNAs), effectively becoming a sink for microRBA miR-145, thereby activating the derepression of core transcription factors Nanog. PMID: 26636540
- ALKBH5 overexpression decreased NANOG mRNA methylation, increased NANOG levels, and increased the percentage of BCSCs, phenocopying the effect of hypoxia PMID: 27001847
- Expression levels of OCT4, SOX2, and NANOG were evaluated by immunohistochemistry with tissue microarray slides of 436 OSCC, 362 corresponding tumor-adjacent normal (CTAN) tissues, and 71 normal uvula epithelium tissues. PMID: 26211876
- Nanog possesses important function in BCSC. PMID: 26339994
- Our study provides new insight into the function of DPPA5 and NANOG regulation in human pluripotent stem cell . PMID: 26661329
- the available data demonstrate that NANOG is strictly involved in the process of carcinogenesis and is a potential prognostic marker of malignant tumors. PMID: 26618281
- the disruption of Nanog expression results in less proliferation, invasiveness, migration, more chemosensitivity and reversal of EMT in HepG2 cells, by which Nanog plays crucial roles in influencing the malignant phenotype of HepG2 cells. PMID: 26676719
- The promoter activity of Nanog and Oct4 were upregulated, and beta-catenin was observed to bind to these promoters during H. pylori infection, while a Wnt/beta-catenin inhibitor suppressed promoter activity and binding. PMID: 26940070
- ectopic expression of Oct-4 gene in hAFMSCs with high self-renewal ability could upregulate Nanog and Sox-2 gene expression PMID: 25385323
- Nanog is an oncogene with multiple roles in promoting tumorigenesis and metastasis PMID: 26073077
- The positive correlation among Oct-4, Nanog, and beta-catenin suggests their coordinated role in maintaining proliferation in oral carcinoma cells. PMID: 24700702
- Oct3/4 and Nanog represent probable CSC markers in HNSCC, which contribute to the development of DNM in part by enhancing cell motility and invasiveness. PMID: 26483189
顯示更多
收起更多
-
亞細胞定位:Nucleus.
-
蛋白家族:Nanog homeobox family
-
組織特異性:Expressed in testicular carcinoma and derived germ cell tumors (at protein level). Expressed in fetal gonads, ovary and testis. Also expressed in ovary teratocarcinoma cell line and testicular embryonic carcinoma. Not expressed in many somatic organs and
-
數據庫鏈接:
Most popular with customers
-
-
YWHAB Recombinant Monoclonal Antibody
Applications: ELISA, WB, IHC, IF, FC
Species Reactivity: Human, Mouse, Rat
-
Phospho-YAP1 (S127) Recombinant Monoclonal Antibody
Applications: ELISA, WB, IHC
Species Reactivity: Human
-
-
-
-
-